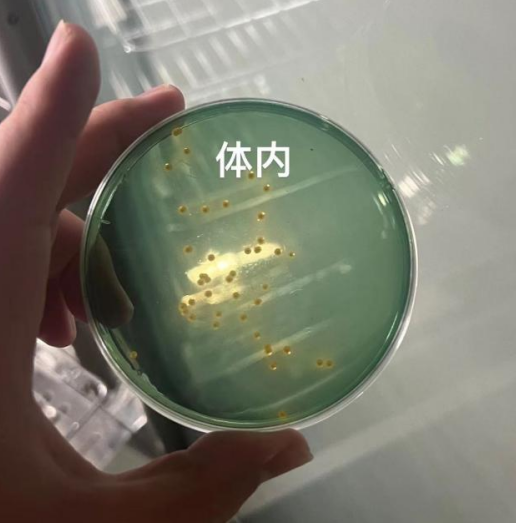
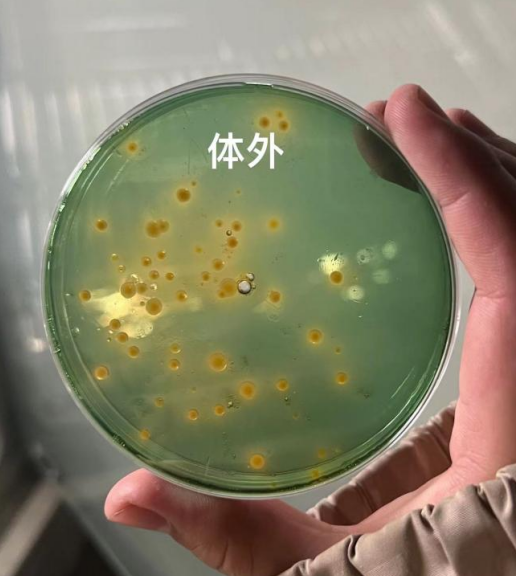

一、案例详情
时间:2023年3月
地点:河北省黄骅市
养殖品种:南美白对虾
水池面积:24㎡
水质指标:pH:8.6 氨氮:0 亚硝酸盐:0.15
情况描述:对虾吃料变慢,个别池子较严重,肝脏发红,空肠空胃。水体弧菌检测:绿弧菌,黄弧菌超标,肝胰腺、肠道弧菌检测:绿弧菌,黄弧菌都严重超标。
二、处理方案
沉淀池消毒:海因先锋3ppm
水体弧菌:外泼弧立净5ppm,情况严重可连用两次。
体内弧菌:绿弧克星内服拌料3g/kg


三、效果反馈
水体绿弧菌、黄弧菌均正常,虾肠道、肝脏弧菌也在正常范围,虾吃料也明显增快。

四、案例分析
弧菌为一种有害菌,其中副溶血弧菌、溶藻弧菌对南美白对虾影响较大。副溶血弧菌:使对虾患上早期死亡综合征;溶藻弧菌:使虾苗患上菌血病,以及红体病、白斑病等病害。
车间养殖温度非常适宜弧菌的繁殖,尤其天气回暖,沉淀池藻类开始变多,弧菌大量繁殖;外源水换水也有可能把弧菌带进车间;池底、池壁不干净,发滑等也容易滋生弧菌。
弧立净:高含量菌粉,菌种纯正,海淡水通用,适应范围广泛,温和无刺激。可高效裂解水体中的副溶血弧菌、溶藻弧菌等有害菌。
绿弧克星:耐温耐高盐、效果稳定持久,专门针对体内绿弧菌。
海因先锋:对水产养殖底层有机污染物及有害微生物具有极好的氧化还原作用,从而抑制水体有害物质的产生。
本文供稿:孙德康
编辑审核:臧学运,张传宝

